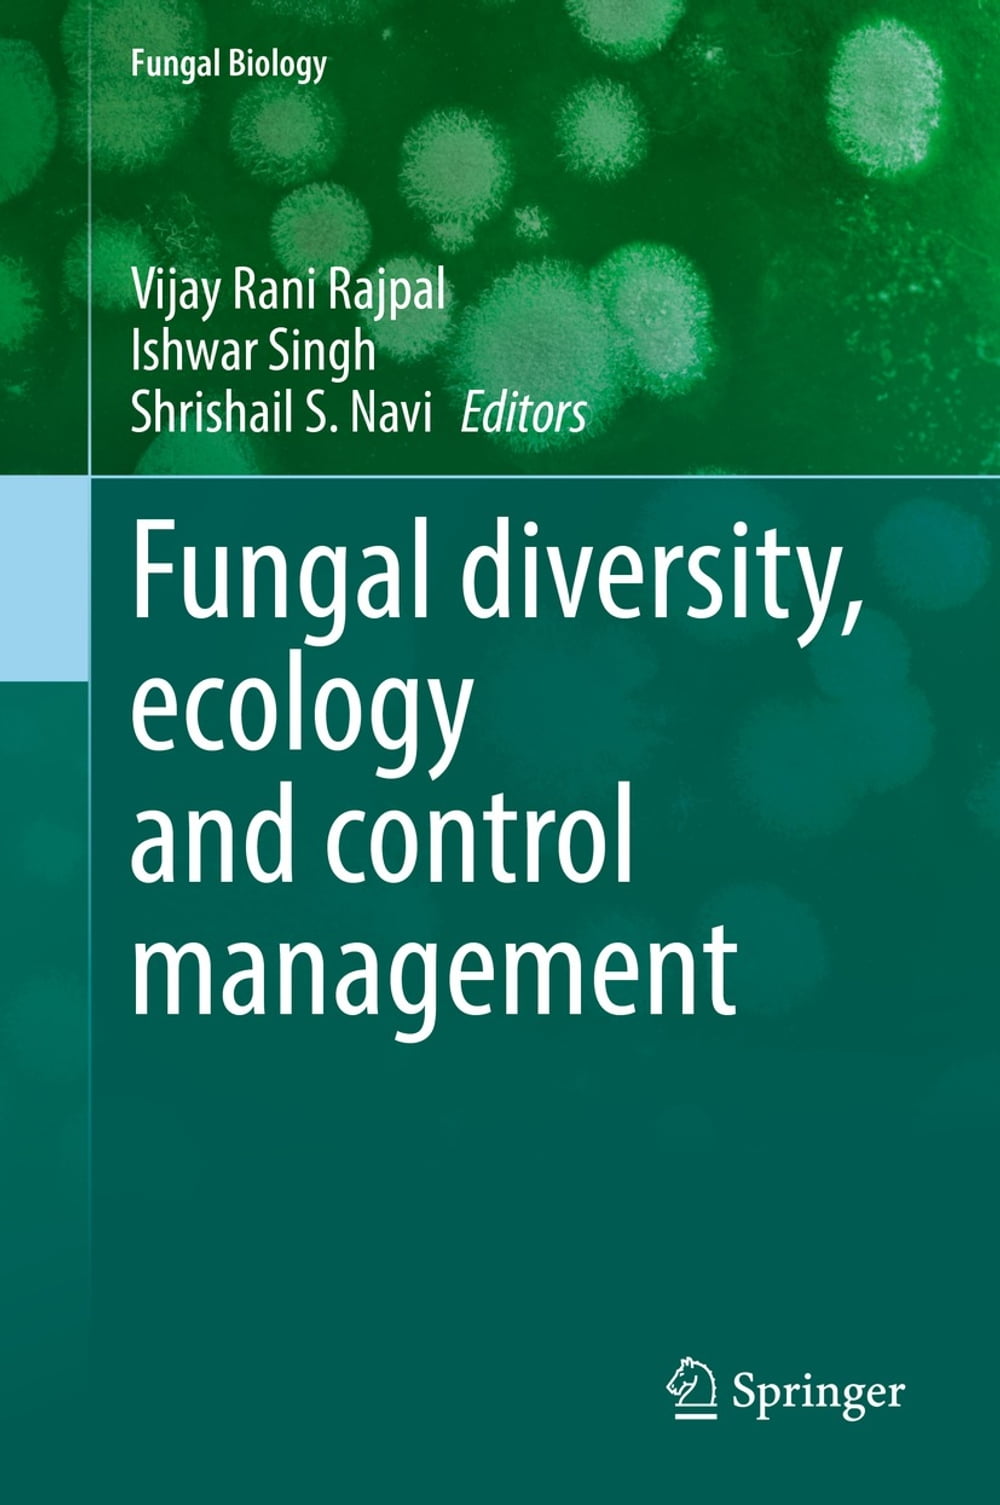
ibs

L’articolo è stato aggiunto alla lista dei desideri
IBS.it, l'altro eCommerce
Fungal diversity, ecology and control management
Cliccando su “Conferma” dichiari che il contenuto da te inserito è conforme alle Condizioni Generali d’Uso del Sito ed alle Linee Guida sui Contenuti Vietati. Puoi rileggere e modificare e successivamente confermare il tuo contenuto. Tra poche ore lo troverai online (in caso contrario verifica la conformità del contenuto alle policy del Sito).
Grazie per la tua recensione!
Tra poche ore la vedrai online (in caso contrario verifica la conformità del testo alle nostre linee guida). Dopo la pubblicazione per te +4 punti
Altre offerte vendute e spedite dai nostri venditori

Tutti i formati ed edizioni
Promo attive (0)
This edited volume provides comprehensive and latest information on the fungal biodiversity in its morphological characters, bioactive molecules, pathogenicity and virulence, and its impacts on crop production and sustainable management of agricultural productivity towards resolving global food security issues. The increasing number of infectious fungal diseases are regarded as threats to agricultural productivity and global food security. The efforts done by scientists to inventories the fungal diversity and identification of fungal species contributing as pathogens towards many plant and human diseases have been compiled in the present volume. The identification of the potential fungal pathogens is a prerequisite for an effective disease control management program. Also important is to understand the complex interactions between the host-pathogen and the environment. The book dwells on insights on the aforementioned aspects. The book also includes articles onecological significance of fungi and fungal antagonists used as biocontrol agents on other pathogens. This compilation is useful to scientists working in similar areas as well as to undergraduate and graduate students keen on getting updated information on the subject. Scientists involved in agricultural research, crop management, and industries that manufacture agrochemicals may also find it useful read.
L'articolo è stato aggiunto al carrello
Formato:
Gli eBook venduti da IBS.it sono in formato ePub e possono essere protetti da Adobe DRM. In caso di download di un file protetto da DRM si otterrà un file in formato .acs, (Adobe Content Server Message), che dovrà essere aperto tramite Adobe Digital Editions e autorizzato tramite un account Adobe, prima di poter essere letto su pc o trasferito su dispositivi compatibili.
Cloud:
Gli eBook venduti da IBS.it sono sincronizzati automaticamente su tutti i client di lettura Kobo successivamente all’acquisto. Grazie al Cloud Kobo i progressi di lettura, le note, le evidenziazioni vengono salvati e sincronizzati automaticamente su tutti i dispositivi e le APP di lettura Kobo utilizzati per la lettura.
Clicca qui per sapere come scaricare gli ebook utilizzando un pc con sistema operativo Windows
L’articolo è stato aggiunto alla lista dei desideri

